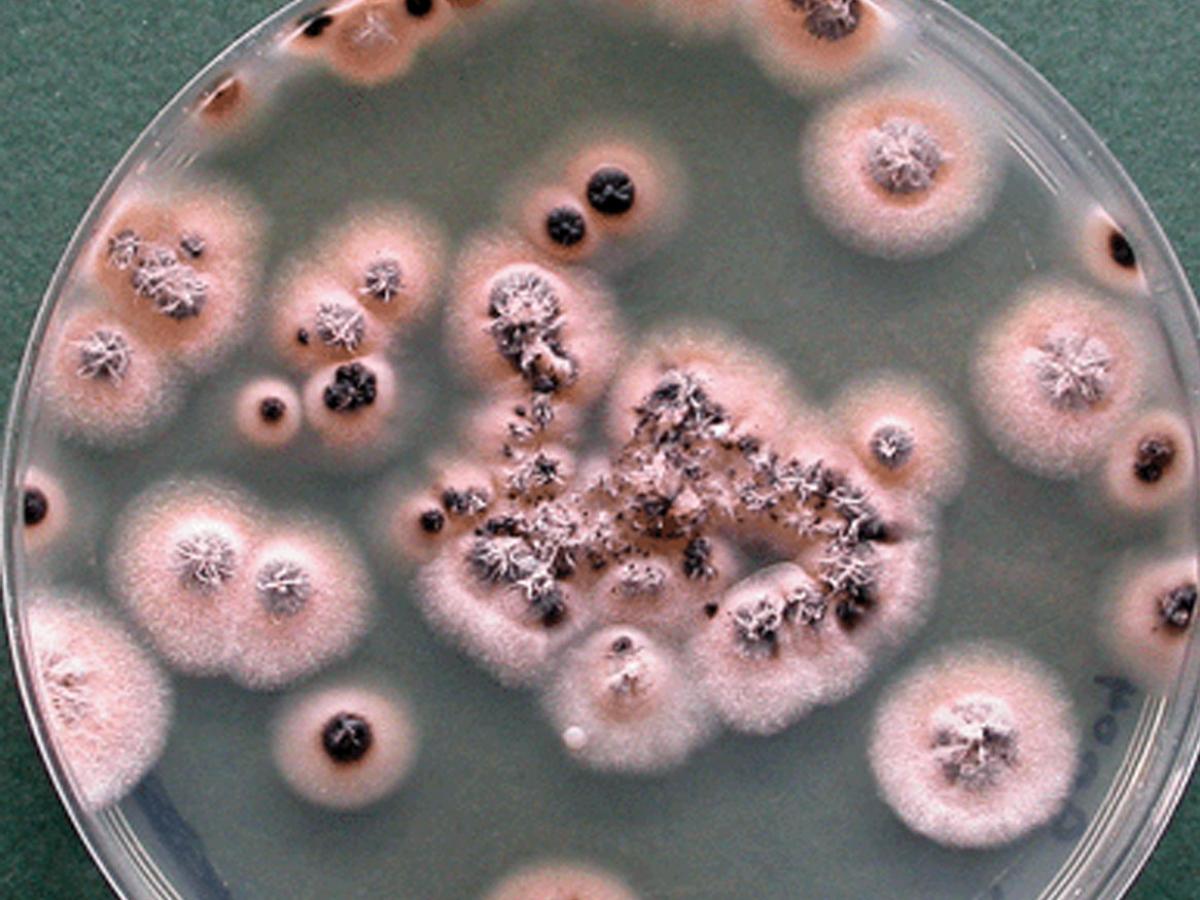
Culture

Status message
Correct! Excellent, you have really done well. Please find additional information below.
Unknown 28 = Coniochaeta hoffmannii
Direct microscopy (PAS): Periodic Acid-Schiff (PAS) stained smear showing septate hyphal elements.

Culture: Colonies are flat, smooth, moist, pink to orange, with regular and sharp margin; reverse pink.
Microscopy: Hyphae are narrow, hyaline, producing conidia laterally from small collarettes directly on the hyphae, or from lateral cells which are sometimes arranged in dense groups; lateral cells flask-shaped or nearly cylindrical. Conidia are hyaline, smooth- and thin-walled, broadly ellipsoidal to cylindrical or allantoid, produced in slimy heads.


Comment: The genus Coniochaeta is morphologically similar to Phialemonium. Coniochaeta hoffmannii has been associated with cases of subcutaneous infections, keratitis, sinusitis, peritonitis, and canine osteomyelitis. Coniochaeta mutabilis has been described to be a causative agent of human peritonitis, endocarditis, endophthalmitis, and keratitis.
About Coniochaeta Back to virtual assessment